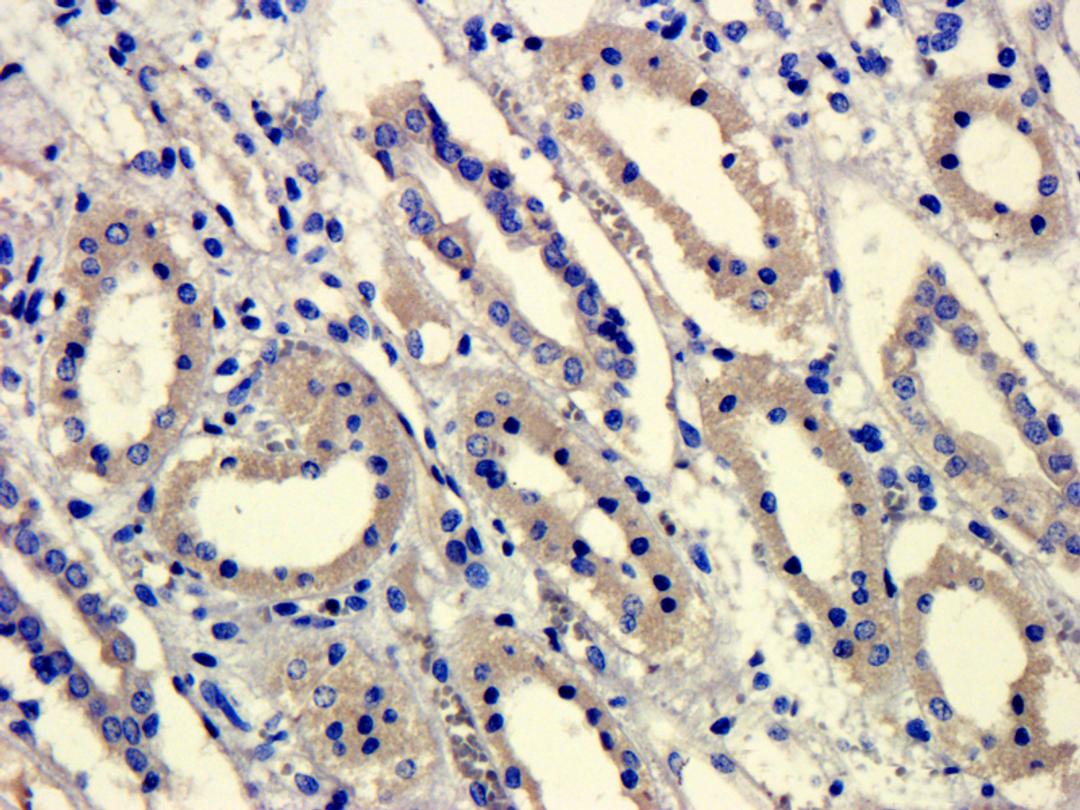
Immunohistochemical staining of paraffin embedded pig kidney tissue using anti-GPR55 (primary antibody at 1: 100)

Product & ReviewsAntibodies
GPR55 antibody
Product Details
- Cat. No.
- orb101191
- Type
- Primary Antibody
- Clonality
- Polyclonal
- Host
- Rabbit

The supplier does not provide quotations for this antibody through SelectScience. You can search for similar antibodies in our Antibody Directory.
Description
Rabbit polyclonal antibody to GPR55 which has been reported to be expressed in the brain; where mRNA transcripts were detected in the caudate nucleus and putamen; but not in five other brain regions. These chemical modifications accumulatelong term complications of diabetes; atherosclerosis and renal failure.
Biological Information
- Clonality: Polyclonal
- Host: Rabbit
- Reactivity: Human, Mouse, Pig (Swine), Rat
- Clone: NULL
- Conjugate: Unconjugated
- Isotype: IgG
- Gene: 9290
Handling
- Quantity: 100 ?g; 200 ?g
- Storage: Store at 4°C for up to two weeks. For long term storage; aliquot and store at -20°C; avoid freeze/thaw cycles.
- Buffer: 10 mM PBS; 0.02% sodium azide
Applications
- ELISA (ELISA)
- Immunofluorescence (IF)
- Immunohistochemistry (Paraffin-Embedded Sections) (IHC (P))
- Western Blotting (WB)